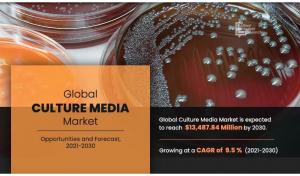

Culture Media Market Set for Explosive Growth, Projected to Reach 13.48 billion by 2030 at a CAGR of 9.5%
PORTLAND, OR, UNITED STATES, February 6, 2025 /EINPresswire.com/ -- Allied Market Research has published a study report with the title Culture Media Market Size was Valued at USD 5.49 billion in 2020 and is Projected to Garner USD 13.48 billion by 2030, registering a CAGR of 9.5% from 2021 to 2030. The report provides a detailed analysis of the top investment pockets, top winning strategies, drivers & opportunities, market size & estimations, competitive landscape, and evolving market trends. The market study is a helpful source of information for the frontrunners, new entrants, investors, and shareholders in crafting strategies for the future and heightening their position in the market.
Increase in R&D investments, surge in advancements associated with cell culture media, and high demand for cell culture media drive the growth of the global culture media market. On the other hand, lack of skilled professionals and scientific concerns associated with culture media restrain the growth to some extent. However, the untapped potential in the emerging economies has been highly beneficial to the industry.
Get Sample PDF Report with Graphs and Figures Here: https://www.alliedmarketresearch.com/request-sample/3979
Top Culture Media Companies
• Avantor Performance Materials
• LLC (VWR International, LLC)
• Becton
• Dickinson and Company (BD)
• Bio-Rad Laboratories Inc. (Bio-Rad)
• Fujifilm Holdings Corporation (Fujifilm)
• Merck & Co., Inc. (Merck)
• Corning Incorporated (Corning)
• GE Healthcare
• HiMedia Laboratories Pvt., Ltd (HiMedia)
• Lonza Group Ltd. (Lonza)
Culture Media Market Segmentation:-
By Type
• Lysogeny broth
• Chemically defined media
• Classical Media
• Serum-free Media
• Specialty Media
• Stem Cell Media
• Custom Media Formulation
• Other media
By Application
• Cancer Research
• Biopharmaceuticals
• Regenerative Medicine & Tissue Engineering
• Stem Cell Technologies
• Drug Discovery
• Other Applications
By Research Type
• Cytogenetics
• Cell Therapy
• Others
By End User
• Biotechnology and Pharmaceutical Industry
• Academic Institute
• Research Laboratory
• Others
Based on region, the market across North America held the lion’s share in 2020, garnering more than two-fifths of the global market. The Asia-Pacific region, however, is expected to cite the fastest CAGR of 10.1% by the end of 2030. The other provinces studied in the report include Europe and LAMEA.
Purchase the Report: https://www.alliedmarketresearch.com/purchase-enquiry/3979
Key Benefits For Stakeholders
• This report provides a detailed quantitative analysis of the current trends and future estimations from 2020 to 2030, which assist to identify the prevailing market opportunities.
• In-depth market analysis includes analysis of various regions, which is anticipated to provide a detailed understanding of the current trends to enable stakeholders to formulate region-specific plans.
• A comprehensive analysis of factors that drive and restrain the growth of the global is provided.
• Region-wise and country-wise market conditions are comprehensively analyzed in this report.
• The projections in this report are made by analyzing the current trends and future market potential from 2020 to 2030, in terms of value.
• An extensive analysis of various regions provides insights that are expected to allow companies to strategically plan their business moves.
• Key market players within the Global Culture Media Market are profiled in this report and their strategies are analyzed thoroughly, which helps in understanding competitive outlook of the market.
Our Market Research Solution Provides You Answer to Below Mentioned Question:
• Which are the driving factors responsible for the growth of market?
• Which are the roadblock factors of this market?
• What are the new opportunities, by which market will grow in coming years?
• What are the trends of this market?
• Which are main factors responsible for new product launch?
• How big is the global & regional market in terms of revenue, sales and production?
• How far will the market grow in forecast period in terms of revenue, sales and production?
• Which region is dominating the global market and what are the market shares of each region in the overall market in 2022?
• How will each segment grow over the forecast period and how much revenue will these segments account for in 2030?
• Which region has more opportunities?
By Region Outlook
• North America
(U.S., Canada, Mexico)
• Europe
(Germany, France, UK, Italy, Spain, Rest of Europe)
• Asia-Pacific
(Japan, China, India, Rest of Asia-Pacific)
• LAMEA
(Brazil, Saudi Arabia, South Africa, Rest of LAMEA)
Contact Details:
David Correa
USA/Canada (Toll Free): +1-800-792-5285, +1-503-894-6022
help@alliedmarketresearch.com
About Us
Allied Market Research (AMR) is a full-service market research and business-consulting wing of Allied Analytics LLP based in Portland, Oregon. Allied Market Research provides global enterprises as well as medium and small businesses with unmatched quality of “Market Research Reports” and “Business Intelligence Solutions.” AMR has a targeted view to provide business insights and consulting to assist its clients to make strategic business decisions and achieve sustainable growth in their respective market domain

Increase in R&D investments, surge in advancements associated with cell culture media, and high demand for cell culture media drive the growth of the global culture media market. On the other hand, lack of skilled professionals and scientific concerns associated with culture media restrain the growth to some extent. However, the untapped potential in the emerging economies has been highly beneficial to the industry.
Get Sample PDF Report with Graphs and Figures Here: https://www.alliedmarketresearch.com/request-sample/3979
Top Culture Media Companies
• Avantor Performance Materials
• LLC (VWR International, LLC)
• Becton
• Dickinson and Company (BD)
• Bio-Rad Laboratories Inc. (Bio-Rad)
• Fujifilm Holdings Corporation (Fujifilm)
• Merck & Co., Inc. (Merck)
• Corning Incorporated (Corning)
• GE Healthcare
• HiMedia Laboratories Pvt., Ltd (HiMedia)
• Lonza Group Ltd. (Lonza)
Culture Media Market Segmentation:-
By Type
• Lysogeny broth
• Chemically defined media
• Classical Media
• Serum-free Media
• Specialty Media
• Stem Cell Media
• Custom Media Formulation
• Other media
By Application
• Cancer Research
• Biopharmaceuticals
• Regenerative Medicine & Tissue Engineering
• Stem Cell Technologies
• Drug Discovery
• Other Applications
By Research Type
• Cytogenetics
• Cell Therapy
• Others
By End User
• Biotechnology and Pharmaceutical Industry
• Academic Institute
• Research Laboratory
• Others
Based on region, the market across North America held the lion’s share in 2020, garnering more than two-fifths of the global market. The Asia-Pacific region, however, is expected to cite the fastest CAGR of 10.1% by the end of 2030. The other provinces studied in the report include Europe and LAMEA.
Purchase the Report: https://www.alliedmarketresearch.com/purchase-enquiry/3979
Key Benefits For Stakeholders
• This report provides a detailed quantitative analysis of the current trends and future estimations from 2020 to 2030, which assist to identify the prevailing market opportunities.
• In-depth market analysis includes analysis of various regions, which is anticipated to provide a detailed understanding of the current trends to enable stakeholders to formulate region-specific plans.
• A comprehensive analysis of factors that drive and restrain the growth of the global is provided.
• Region-wise and country-wise market conditions are comprehensively analyzed in this report.
• The projections in this report are made by analyzing the current trends and future market potential from 2020 to 2030, in terms of value.
• An extensive analysis of various regions provides insights that are expected to allow companies to strategically plan their business moves.
• Key market players within the Global Culture Media Market are profiled in this report and their strategies are analyzed thoroughly, which helps in understanding competitive outlook of the market.
Our Market Research Solution Provides You Answer to Below Mentioned Question:
• Which are the driving factors responsible for the growth of market?
• Which are the roadblock factors of this market?
• What are the new opportunities, by which market will grow in coming years?
• What are the trends of this market?
• Which are main factors responsible for new product launch?
• How big is the global & regional market in terms of revenue, sales and production?
• How far will the market grow in forecast period in terms of revenue, sales and production?
• Which region is dominating the global market and what are the market shares of each region in the overall market in 2022?
• How will each segment grow over the forecast period and how much revenue will these segments account for in 2030?
• Which region has more opportunities?
By Region Outlook
• North America
(U.S., Canada, Mexico)
• Europe
(Germany, France, UK, Italy, Spain, Rest of Europe)
• Asia-Pacific
(Japan, China, India, Rest of Asia-Pacific)
• LAMEA
(Brazil, Saudi Arabia, South Africa, Rest of LAMEA)
Contact Details:
David Correa
USA/Canada (Toll Free): +1-800-792-5285, +1-503-894-6022
help@alliedmarketresearch.com
About Us
Allied Market Research (AMR) is a full-service market research and business-consulting wing of Allied Analytics LLP based in Portland, Oregon. Allied Market Research provides global enterprises as well as medium and small businesses with unmatched quality of “Market Research Reports” and “Business Intelligence Solutions.” AMR has a targeted view to provide business insights and consulting to assist its clients to make strategic business decisions and achieve sustainable growth in their respective market domain
David Correa
Allied Market Research
+ + 1 800-792-5285
email us here
Visit us on social media:
Facebook
X
LinkedIn
YouTube
Legal Disclaimer:
EIN Presswire provides this news content "as is" without warranty of any kind. We do not accept any responsibility or liability for the accuracy, content, images, videos, licenses, completeness, legality, or reliability of the information contained in this article. If you have any complaints or copyright issues related to this article, kindly contact the author above.